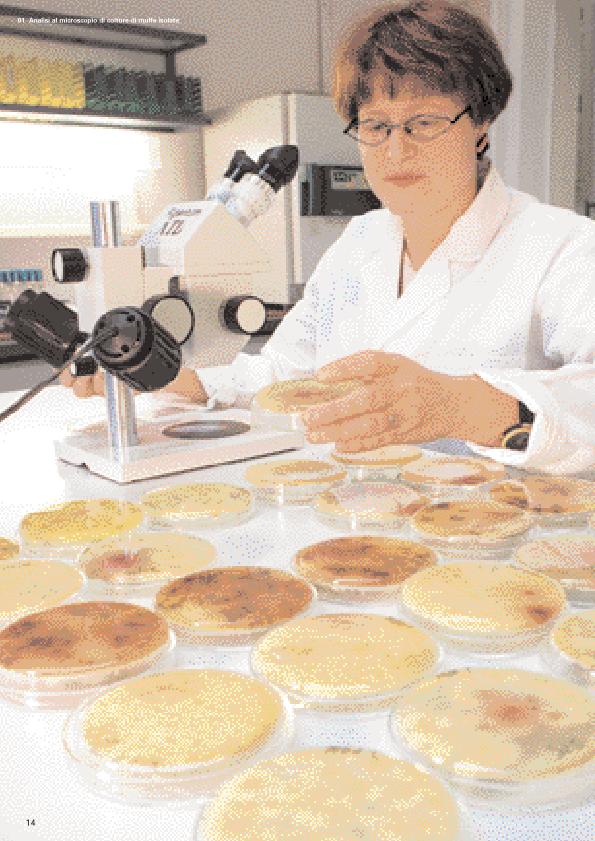

El Moho tóxico gana terreno : un gran desafío para la industria aseguradora
- Koegel, Andrew
- En: Schaden Spiegel : boletín de siniestros. - Munich : Münchener Rück, Munich Re Group, 1977-2011 = ISSN 0941-6595. - 01/03/2003 Número 1 Marzo 2003, p. 14-19
- Artículos y Capítulos